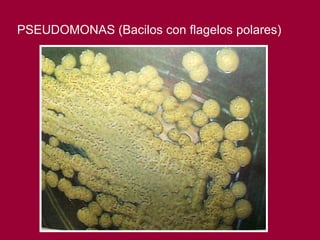
PSEUDOMONAS (Bacilos con flagelos polares)

Este documento presenta una lista de organismos vivos pertenecientes a diferentes dominios y reinos, incluyendo bacterias, algas, hongos, líquenes, protistas, animales invertebrados y vertebrados. Describe brevemente las características de cada organismo, como su estructura, filiación y hábitat. El objetivo es mostrar la gran diversidad del mundo vivo a través de numerosos ejemplos de especies micro y macroscópicas.